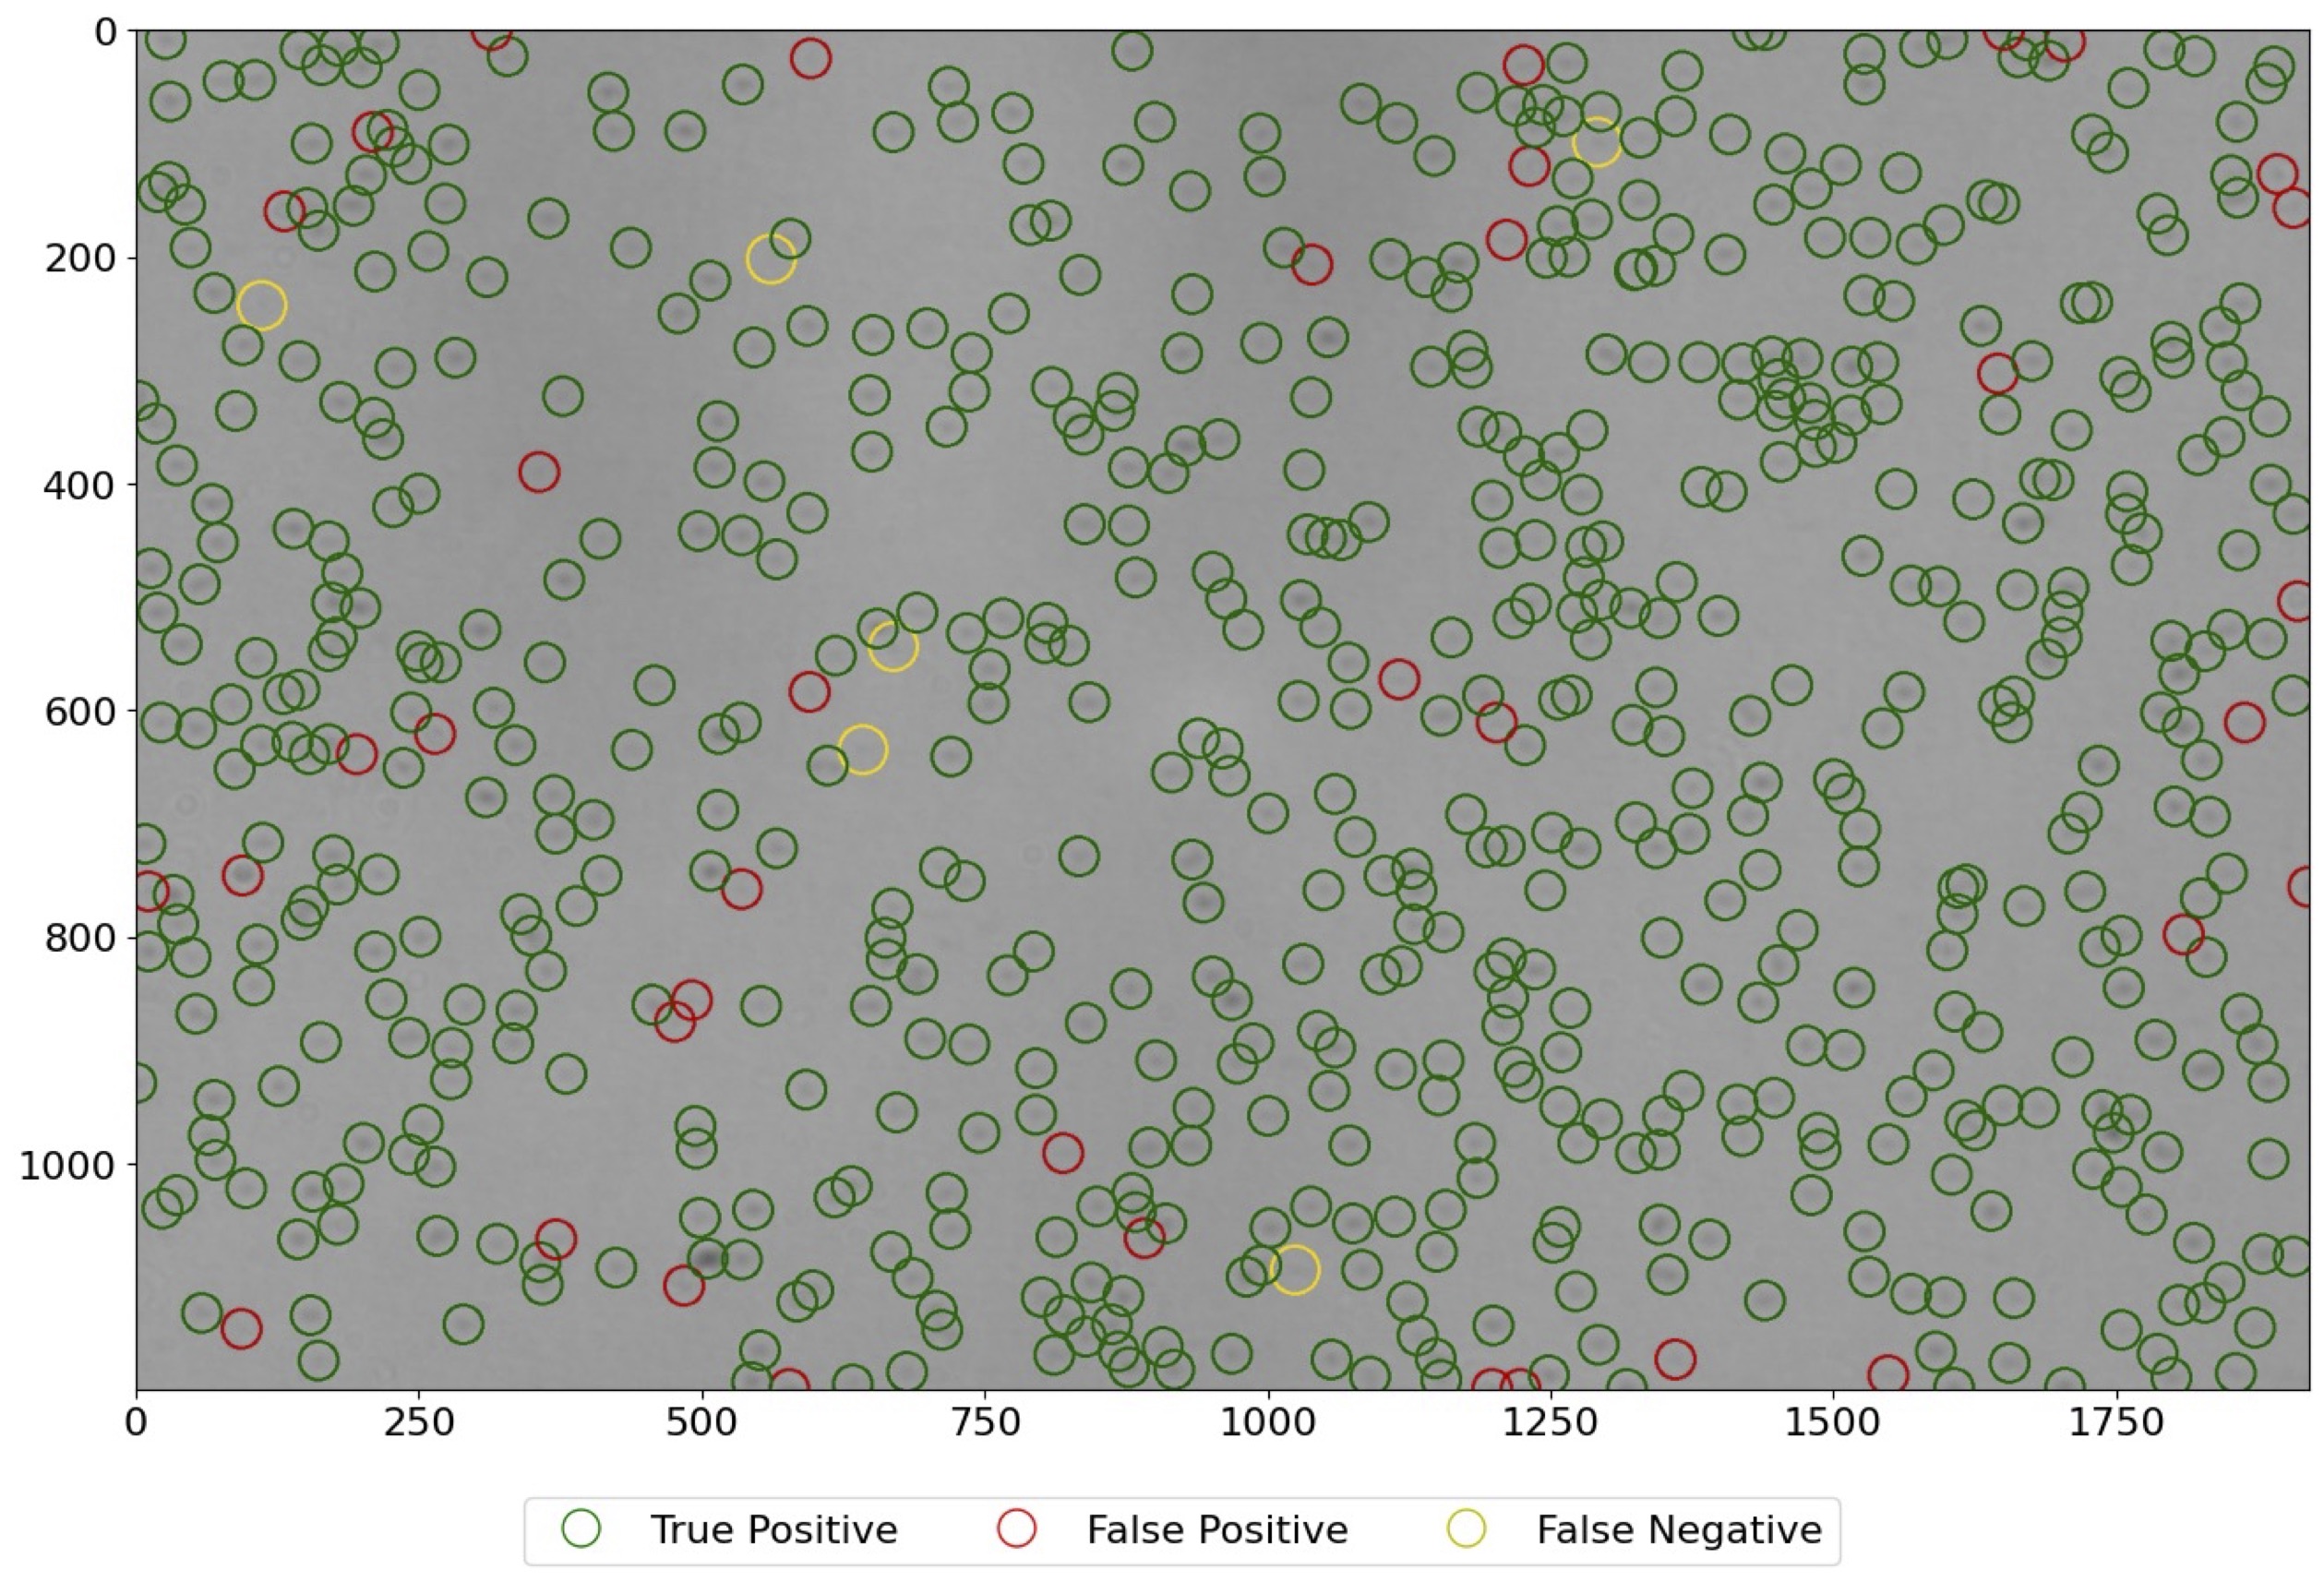
PRAM Demo

plugin for PRAM data annotation and processing
Project description
napari-pram
Plugin for PRAM data annotation and processing.
This napari plugin was generated with Cookiecutter using @napari's cookiecutter-napari-plugin template.
Usage
Open napari-pram toolbox:
On the toolbar, select [Plugins] > napari-pram: Open PRAM's toolbox
Load PRAM image and annotations:
Press Command/Control + O:
- Select
*.jsonfiles for annotations (from either VGG Annotator ornapari-pram) - Select
*.pngfiles for PRAM image
Annotate
- Press Annotate
- Click the plus-in-circle icon on the top-left panel and start editing
Run PRAM particles detector
- Select a proper threshold between 1 (ultra sensitive) - 10 (less sensitive)
- Press Run Detector
Evaluate
- Press Evaluate
- Hide/Unhide true positive/ false postive/false negative layers
Load new image
- Press Clear All to remove all layers
Export to JSON
- Press Save to File to export all annotations, predictions from the algorithm to a JSON file
Installation
Following this tutorial to install napari.
Alternatively, you can follow my instructions as follows:
You will need a python environment. I recommend Conda. Create a new environment, for example:
conda create --name napari-env python=3.7 pip
Activate the new environment:
conda activate napari-env
pip install napari[all]
Then you can finally install our plugin napari-pram via pip:
pip install napari-pram
Alternatively, the plugin can be installed using napari-GUI
[Plugins] > Install/Uninstall Plugins and search for napari-pram
Contributing
Contributions are very welcome. Tests can be run with tox, please ensure the coverage at least stays the same before you submit a pull request.
License
Distributed under the terms of the MIT license, "napari-pram" is free and open source software
Issues
If you encounter any problems, please [file an issue] along with a detailed description.
Project details
Download files
Download the file for your platform. If you're not sure which to choose, learn more about installing packages.
Source Distribution
Built Distribution
Filter files by name, interpreter, ABI, and platform.
If you're not sure about the file name format, learn more about wheel file names.
Copy a direct link to the current filters
File details
Details for the file napari_pram-0.1.3.tar.gz.
File metadata
- Download URL: napari_pram-0.1.3.tar.gz
- Upload date:
- Size: 12.1 kB
- Tags: Source
- Uploaded using Trusted Publishing? No
- Uploaded via: twine/4.0.0 CPython/3.7.10
File hashes
| Algorithm | Hash digest | |
|---|---|---|
| SHA256 |
27a4c1e2b386b91d641da7a1369d56184c71553fde442c2e8d9371f0890c7727
|
|
| MD5 |
370443b176930a6db61d1c58b9eb7c97
|
|
| BLAKE2b-256 |
8acffb51fba087474428115303871dbd32eea0eee818b033180d641587988b62
|
File details
Details for the file napari_pram-0.1.3-py3-none-any.whl.
File metadata
- Download URL: napari_pram-0.1.3-py3-none-any.whl
- Upload date:
- Size: 13.9 kB
- Tags: Python 3
- Uploaded using Trusted Publishing? No
- Uploaded via: twine/4.0.0 CPython/3.7.10
File hashes
| Algorithm | Hash digest | |
|---|---|---|
| SHA256 |
911602d5e8f3e07f1a2e67fb8601789dcda6c4914be3b6b646849013b4dc7afd
|
|
| MD5 |
44c1cfab5efaff66b7f56a6f222aef19
|
|
| BLAKE2b-256 |
136a0d393feb3a9ca5faec3b0ed332c71452e8b5d2e48238b8aa9966faaa7a2e
|